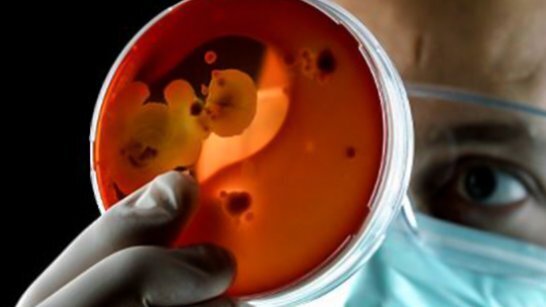
Streptococco, i consigli degli esperti

Nel nuovo numero di “A scuola di salute” le indicazioni su come comportarsi quando si è in presenza di infezioni da streptococco. Un tempo rappresentavano un autentico problema sociale, il terrore dei genitori. In seguito, con il migliorare delle condizioni di vita e la diffusione degli antibiotici, hanno smesso di fare paura. Le complicanze, tuttavia, ancora oggi non vanno sottovalutate, tanto più che l’abuso di terapie antibiotiche inappropriate ha prodotto "resistenze" che stanno indebolendo l’efficacia dell’azione di contrasto.
Se ne parla nell’ultimo numero di “A Scuola di Salute”, il magazine digitale realizzato dall’Istituto Bambino Gesù per la Salute del Bambino e dell’Adolescente, diretto dal prof. Alberto G. Ugazio. Lo streptococco è un batterio di forma sferica (cocco) di cui esistono vari tipi, molti dei quali non provocano malattie. In alcuni casi, tuttavia, possono causare faringotonsilliti, otiti, meningiti, polmoniti, infezioni generalizzate ed endocarditi (infezioni della cavità interne o delle valvole del cuore). Anche la scarlattina, la malattia reumatica e un’infiammazione del rene (glomerulonefrite) sono causate dallo streptococco.
Il mal di gola è tra i sintomi più frequenti nei bambini e negli adulti con un’infezione delle alte vie respiratorie. Il dolore è un segno dell’infiammazione che può coinvolgere la faringe (faringite) o anche le tonsille (faringotonsillite). Queste ultime possono essere aumentate di volume, arrossate e ricoperte da un materiale biancastro (essudato). Si tratta, cioè, delle cosiddette “placche”, causate dalla reazione del sistema immunitario all’infezione. Tuttavia le “placche” non sono sinonimo di streptococco e possono comparire anche in occasione di infezioni virali come, ad esempio, la mononucleosi. Per questo se ci sono placche sulle tonsille non bisogna mai iniziare la terapia antibiotica senza prima aver verificato la presenza dello streptococco con un tampone. Nella maggioranza dei casi, il mal di gola ha un’origine virale e pertanto non necessita di alcun trattamento. In genere faringiti e faringotonsilliti causate da virus sono accompagnate da altri segni tipici delle malattie virali, come raffreddore, congiuntivite, raucedine o diarrea.
Le uniche faringotonsilliti che richiedono trattamento antibiotico sono quelle di origine batterica, causate dallo streptococco beta emolitico di gruppo A (SBEGA). L’antibiotico di scelta è sempre l’amoxicillina, da somministrarsi per bocca per 10 giorni. La terapia antibiotica deve iniziare entro 9 giorni dal manifestarsi del mal di gola, ma non prima di aver eseguito il cosiddetto tampone, l’esame microbiologico del cavo faringeo. Si tratta di un prelievo che viene effettuato sfregando energicamente tamponi simili a grandi “cotton-fioc” sull’orofaringe e sulla superficie di entrambe le tonsille, evitando di toccare altre parti della cavità orale o di contaminarlo con la saliva. La terapia può abbreviare e attenuare il mal di gola, ma ha in primis lo scopo di prevenire le complicanze.
La malattia reumatica invece è una malattia infiammatoria acuta che si manifesta dopo un’infezione da streptococco SBEGA. In genere si presenta con febbre, dolori e gonfiori articolari. Può interessare anche il cuore, colpendo tipicamente le valvole cardiache (mitralica e aortica) e il sistema nervoso centrale, causando movimenti involontari soprattutto degli arti (la corea di Sydenham, definita più comunemente “Ballo di San Vito”). Viene riscontrata con maggiore frequenza fra i 5 e i 15 anni, mentre è assai rara al di sotto dei 4 anni. La diagnosi della Malattia Reumatica si effettua grazie ai criteri diagnostici di Jones, che includono tra gli altri l’interessamento valvolare da malattia reumatica dimostrato mediante ecocardiografia. Il trattamento della fase acuta si basa sull’eradicazione dello streptococco SBEGA tramite antibiotico, sull’uso di antiinfiammatori non steroidei (per eliminare febbre e dolori articolari) e su un breve ciclo di cortisonici in caso di coinvolgimento del cuore.
Le infezioni da streptococco sono associate anche alle Pandas, acronimo inglese con cui si identificano i disordini neuropsichiatrici autoimmuni associati. Questi rari disordini riguardano l’età pediatrica, in genere tra i 2 e i 12 anni, si manifestano con tic o altri comportamenti compulsivi, esordio improvviso e acuto dopo un’infezione da streptococco SBEGA (per esempio una tonsillite o una scarlattina), periodi di remissione e anomalie neurologiche come iperattività motoria o movimenti involontari. Nonostante le Pandas siano note da diverso tempo, non c’è assoluta certezza che l’infezione da streptococco sia l’unica causa, o comunque la principale, alla base di questo tipo di disordine.
Tag:
«Negli ultimi anni si è assistito ad un progressivo ed esponenziale aumento del contenzioso anche in campo odontoiatrico. Le branche ...
Tempo di scadenze elettorali per i Consigli Direttivi degli Ordini provinciali: il presidente della FNOMCeO, Amedeo Bianco, invia a tutti gli iscritti una ...
Il 2° GBR Symposium ha preso il via venerdì 14 e sabato 15 ottobre allo Zanhotel Centergross di Bologna, sede funzionale, lontana da distrazioni ...
BOSTON, USA: Circa 120 partecipanti provenienti da 27 Paesi si sono riuniti a Boston dal 16 al 18 giugno per un momento storico nell’odontoiatria ...
Sono di origine cilena i dentisti che avrebbero creato una sostanza utilizzabile in dentifrici, collutori, gomme da masticare e altri prodotti per ...
Ieri, 20 marzo, si è celebrata in tutto il mondo la Giornata Mondiale della Prevenzione Dentale, promossa dall’Fdi World Dental Federation per ...
L’ipersensibilità dentinale viene definita come una “sensazione di dolore, breve e intensa, evocata da stimoli fisici o chimici non ...
Il Consiglio di Stato ha accolto il ricorso di Confprofessioni contro l'esclusione dei professionisti dagli ammortizzatori sociali. Palazzo Spada: ...
ISTANBUL, Turchia: Il Prof. Gerry McKenna è membro della facoltà della Scuola di Medicina, Odontoiatria e Scienze Biomediche della Queen’s University ...
Dental Tribune intervista Aldo Bruno Giannì, Giovanna Perrotti e Tiziano Testori.
Live webinar
lun. 15 giugno 2026
17:00 (CET) Rome
Dr. Cristian Scognamiglio, Dr. Alessandro Perucchi
Live webinar
mar. 16 giugno 2026
16:00 (CET) Rome
Elke Schilling Dentalhygienikerin, B.A. Medical Care Management
Live webinar
mer. 17 giugno 2026
1:00 (CET) Rome
Prof. Dr. Wael Att, Dr. Robert A. Levine DDS, FCPP, FISPPS, AOD, Dr. Victor Astolfi Gonzalez-Mogena ITI Scholar Columbia
Live webinar
mer. 17 giugno 2026
14:00 (CET) Rome
Live webinar
mer. 17 giugno 2026
18:00 (CET) Rome
Dr. Roy Samuelsson, Dr. Robert Gottlander DDS
Live webinar
gio. 18 giugno 2026
1:30 (CET) Rome
Live webinar
gio. 18 giugno 2026
17:00 (CET) Rome
Dr. Maximiliano Cacciacane Garcia



 Austria / Österreich
Austria / Österreich
 Bosnia ed Erzegovina / Босна и Херцеговина
Bosnia ed Erzegovina / Босна и Херцеговина
 Bulgaria / България
Bulgaria / България
 Croazia / Hrvatska
Croazia / Hrvatska
 Repubblica Ceca e Slovacchia / Česká republika & Slovensko
Repubblica Ceca e Slovacchia / Česká republika & Slovensko
 Francia / France
Francia / France
 Germania / Deutschland
Germania / Deutschland
 Grecia / ΕΛΛΑΔΑ
Grecia / ΕΛΛΑΔΑ
 Ungheria / Hungary
Ungheria / Hungary
 Italia / Italia
Italia / Italia
 Paesi Bassi / Nederland
Paesi Bassi / Nederland
 nordisch / Nordic
nordisch / Nordic
 Polonia / Polska
Polonia / Polska
 Portogallo / Portugal
Portogallo / Portugal
 Romania e Moldavia / România & Moldova
Romania e Moldavia / România & Moldova
 Slovenia / Slovenija
Slovenia / Slovenija
 Serbia e Montenegro / Србија и Црна Гора
Serbia e Montenegro / Србија и Црна Гора
 Spagna / España
Spagna / España
 Svizzera / Schweiz
Svizzera / Schweiz
 Turchia / Türkiye
Turchia / Türkiye
 Gran Bretagna e Irlanda / UK & Ireland
Gran Bretagna e Irlanda / UK & Ireland
 Internazionale / International
Internazionale / International
 Brasile / Brasil
Brasile / Brasil
 Canada / Canada
Canada / Canada
 America Latina / Latinoamérica
America Latina / Latinoamérica
 USA / USA
USA / USA
 Cina / 中国
Cina / 中国
 India / भारत गणराज्य
India / भारत गणराज्य
 Pakistan / Pākistān
Pakistan / Pākistān
 Vietnam / Việt Nam
Vietnam / Việt Nam
 ASEAN / ASEAN
ASEAN / ASEAN
 Israel / מְדִינַת יִשְׂרָאֵל
Israel / מְדִינַת יִשְׂרָאֵל
 Algeria, Marocco e Tunisia / الجزائر والمغرب وتونس
Algeria, Marocco e Tunisia / الجزائر والمغرب وتونس
 Medio Oriente / Middle East
Medio Oriente / Middle East

Nell’ottica di ridurre la frequenza di tonsilliti da streptococco beta emolitico ricordo l’esistenza e la sperimentazione anche a Milano protocolli preventivi a base di di probiotici specifici ( Streptococcus Salivarius K12)
Dottor Giulio Calderoli